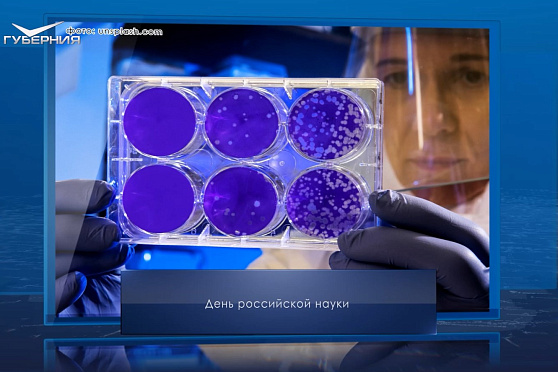
День российской науки. Календарь Губернии от 8 февраля

Календарь губернии
Полная картина дня: праздничные даты, исторический дайджест, обзор прессы, юбилеи и дни рождения известных людей, яркие эпизоды из их жизни. Основа ежедневного календаря знаменательных дат - архивные данные, комментарии историков и уникальные видеозаписи.
Все выпуски этой программы можно посмотреть здесь.
- Пн
- Вт
- Ср
- Чт
- Пт
- Сб
- Вс